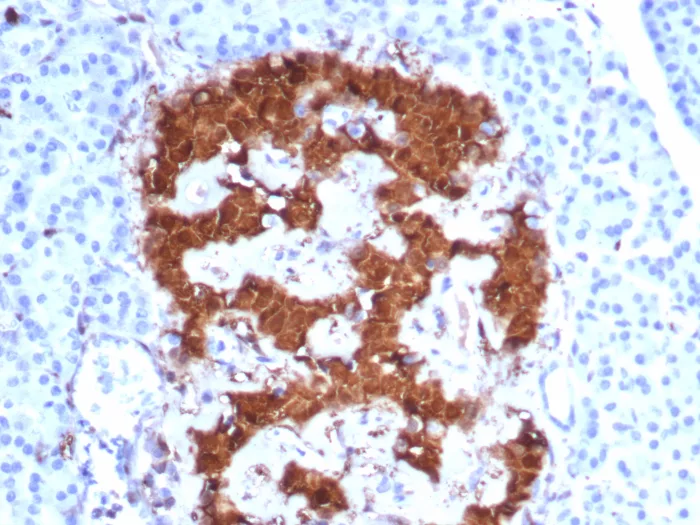

SDS-PAGE Analysis of Purified Pgp9.5 Mouse Monoclonal Antibody (UCHL1/8152). Confirmation of Purity and Integrity of Antibody.

Formalin-fixed, paraffin-embedded human cerebellum stained with Pgp9.5 Mouse Monoclonal Antibody (UCHL1/8152). Inset: PBS instead of primary antibody; secondary only negative control.
Formalin-fixed, paraffin-embedded human pancreas stained with Pgp9.5 Mouse Monoclonal Antibody (UCHL1/8152). HIER: Tris/EDTA, pH9.0, 45min. 2°C: HRP-polymer, 30min. DAB, 5min.
This MAb reacts with a protein of 20-30kDa, identified as PGP9.5, also known as ubiquitin carboxyl-terminal hydrolase-1 (UchL1). Initially, PGP9.5 expression in normal tissues was reported in neurons and neuroendocrine cells but later it was found in distal renal tubular epithelium, spermatogonia, Leydig cells, oocytes, melanocytes, prostatic secretory epithelium, ejaculatory duct cells, epididymis, mammary epithelial cells, Merkel cells, and dermal fibroblasts. Furthermore, immunostaining for PGP9.5 has been shown in a wide variety of mesenchymal neoplasms as well. A mutation in PGP9.5 gene is believed to cause a form of Parkinson’s disease.
There are no reviews yet.